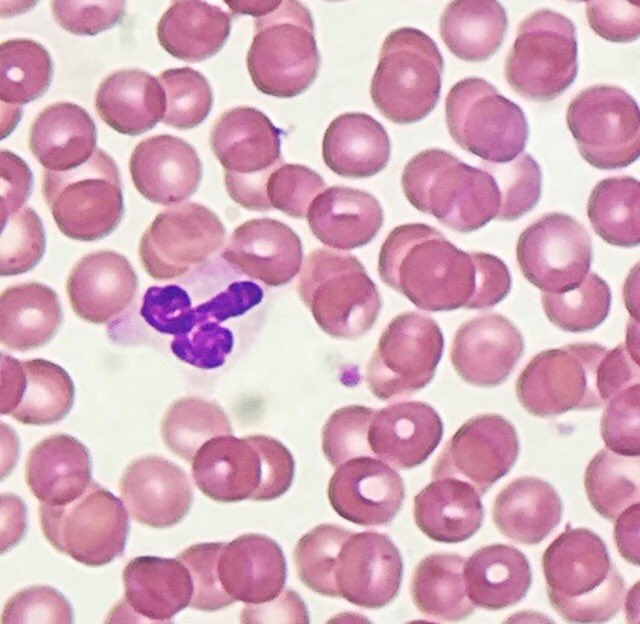
<a href="/IHeartHisto/">I Heart Histo</a> I’m not sure what to think this one is saying 😜<a href="/IHeartHisto/">I Heart Histo</a>  #WorldEmojiDay

drMoh
@path_insitu
PGY-3 Pathology Resident
UPR-MSC;
Neuropathologist in situ ...
🇵🇸🇵🇷
ID: 987425069096947712
20-04-2018 20:17:36
38 Tweet
260 Takipçi
54 Takip Edilen

I Heart Histo I’m not sure what to think this one is saying 😜I Heart Histo #WorldEmojiDay

The most beautiful gout picture I have ever seen! From Theresa Smith of #SoMeDocs (lucky picture from a new scope and polarizer on embedded tissue). Ten important facts about gout here: creakyjoints.org/treatment/teng… #pathart The Pathologist Human Pathology


Recent changes to WHO classification of squamous intra-epithelial lesions of the head and neck discussed in this month's Arch Pathol Lab Med buff.ly/2KKKkAR




Sanjay Mukhopadhyay Sinchita Roy MD PhD Jerad Gardner, MD Marcos Lepe Xiaoyin "Sara" Jiang, MD (She/Her) @CArnold_GI Zubair Baloch Mrs. Kamado Maren Y. Fuller is not here Eduardo Alcaraz, MD PhD Güliz Akdaş Barkan Esther Diana Rossi Tania Labiano Kamran Mirza MD PhD - کامران مرزا Julie Feldstein,MD My definition of #pathologist 👩🏻⚕️😁






#neuropathology conference with the #LivingLegend Dr. J.L Perez-Berenguer Today's topic: Astrocytic lesions/tumors #pathology #neuropath #neuro #residentlife #PerezBerenguer Karra Jones, MD, PhD Fausto Rodriguez AANP Hopkins Neuropath






MARIBEL DONASTORG VITTINI Pembe Oltulu, MD The dx is T-cell lymphoblastic lymphoma. Not all starry sky pattern is Burkitt.

@bansar_bansaria Woo Cheal Cho, MD Bin Xu Sanjay Mukhopadhyay Jerad Gardner, MD Kalyani Bambal Xiaoyin "Sara" Jiang, MD (She/Her) @DrFNA Vijay Shankar S Bunina bodies in motor neurons of the anterior horn in ALS








